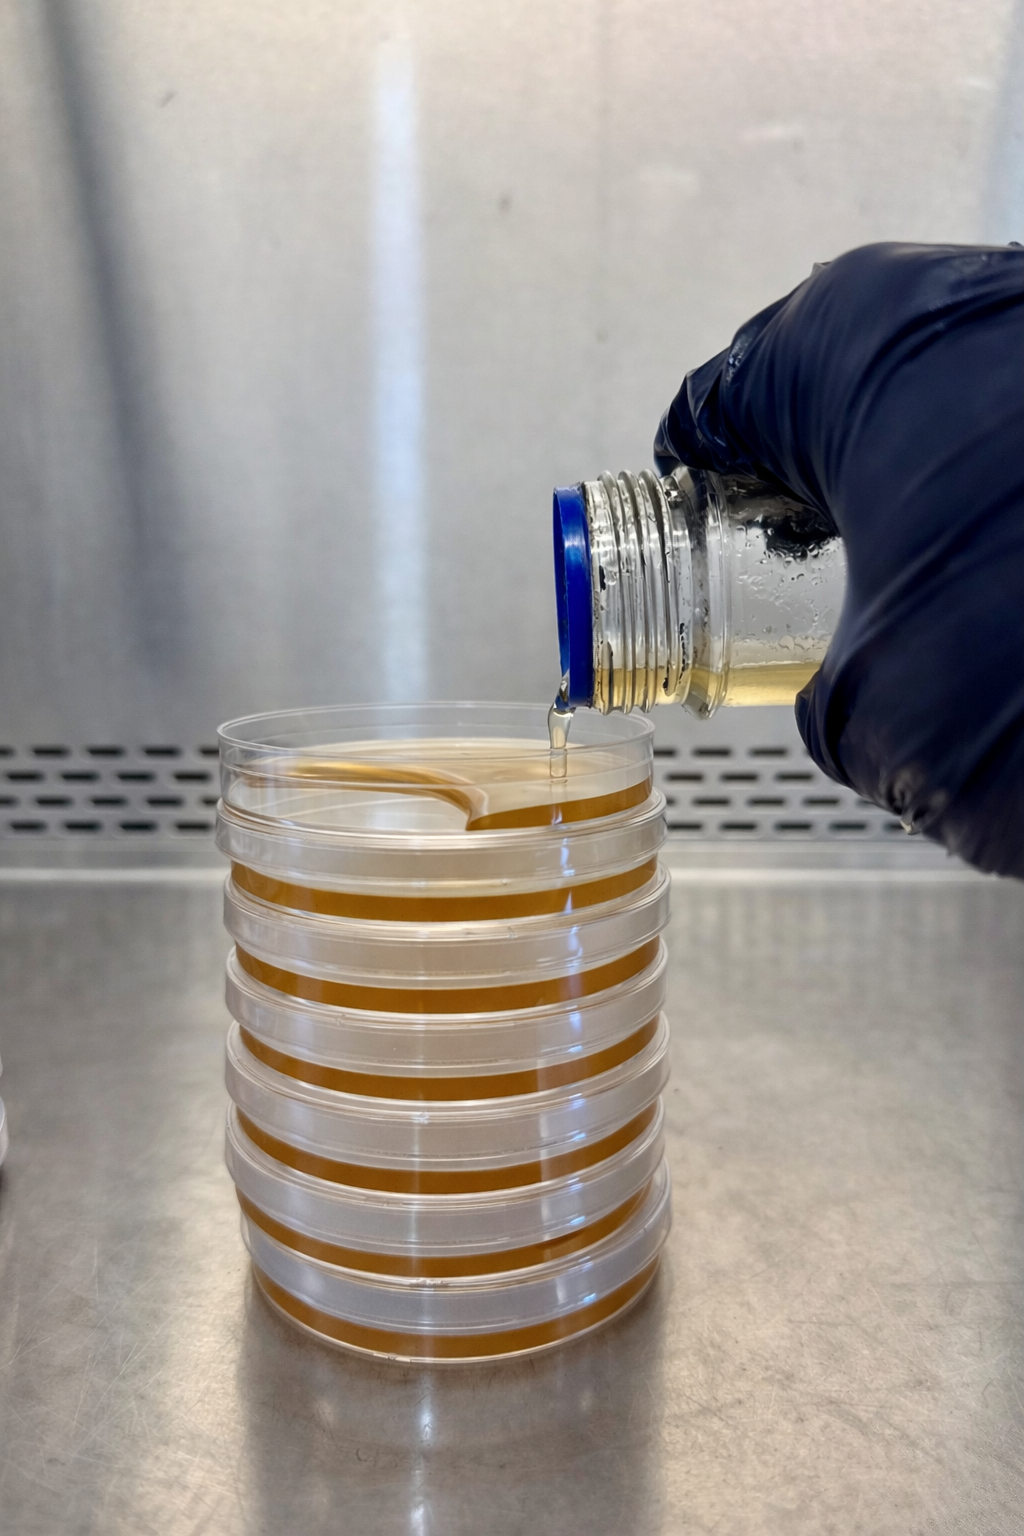

Agar Tutorial
This page contains everything you need to know to pour perfection using DrMyc Platemate Agar.
Thanks for your business & thanks for shopping small!
What's Needed:
- DrMyc Platemate Agar - Distilled or R.O. Water - Flask or Vessel to Sterilize - Stir Bar or Marble - Petri Dishes - Parafilm Tape - Isopropyl Alcohol 70% - Gram Scale - Clean Air Environment (Flowhood)
What's Nice to Have:
-Stir Plate if using Stir Bar - Laser Thermometer - Erlenmeyer flask with Blue Lid (auto pressure relief)


How to Make the Perfect Agar:
-Add 250ml of boiling water (per 10 plates desired, each plate ≈ 25 mL)
-Weigh out 12.5 grams of agar per 250 mL of water used
-Add 12.5 grams of Agar Powder to sterilization Vessel (leave lid 1/4 turn loose to allow for expansion)
-Sterilize agar/water mixture for 45 minutes at 1 bar (≈14 PSI)
- Once 45 minutes is over, let pressure vessel cool. DO NOT remove PC weight, or manually vent the pressure vessel


-Wearing gloves sanitized with ISO 70, carefully remove agar & place clean air environment as soon as cool enough to touch
-Agitate Agar mixture continuously with stir-bar (or marble if used)
-Wait until Temperature is 50 C or 120 F
-Remove petri dishes from sleeve after wiping down sleeve with ISO 70, and leave in a stack of 10 dishes
- Pour Agar into the stack of Petri Dishes, starting at the bottom of the pile of 10 - (this takes some practice and coordination)
- You may also remove the Petri Dishes individually from the stack and pour, but the above method minimizes contam risk
- Once agar solidifies, leave to cool for 2 hours to minimize condensation
- Either use plates immediately, or wrap with Parafilm for storage in Clean Air Environment.
Congratulations - you've now poured the perfect petri dishes! Now enjoy your creations!
If you love our Agar, please rate us 5* on Amazon - we're a 2 person USA based company and they really help us compete with larger businesses.
Mush Love - John & Ian (the DrMyc Team)
